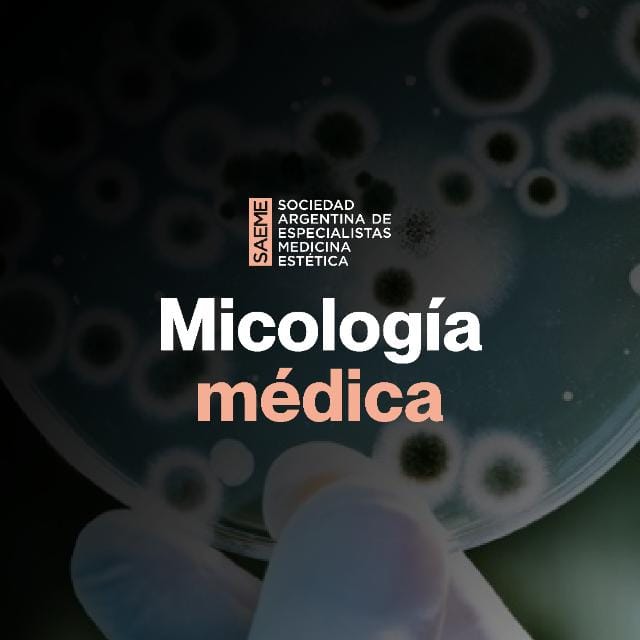
Curso micología médica

Programa clínico solo para médicos que ya se formaron con SAEME
Hormonas Bioidénticas · GinecologíaRegenerativa · Medicina Funciona
Al finalizar el programa podrás:
Integrar hongos medicinales a tratamientos hormonales,
ginecológicos y funcionales.
Elegir el hongo correcto según el perfil del paciente (metabólico,
inmune, neurológico, piel, mucosas, etc.).
Manejar posología, formas de uso, calidad del producto e
interacciones básicas.
Diseñar protocolos micoterapéuticos claros y aplicables
desde el día siguiente.
Course Features
- Lectures 11
- Quiz 0
- Duration 10 semanas
- Skill level Experto
- Language Español
- Students 53
- Assessments Yes
- 8 secciones
- 11 lecciones
- 10 semanas
- Material de lectura4
- MAPA CONCEPTUAL GENERAL1
- Video clase 11
- Video clase 21
- Video clase 31
- Video clase 41
- Video clase 51
- Video clase 61